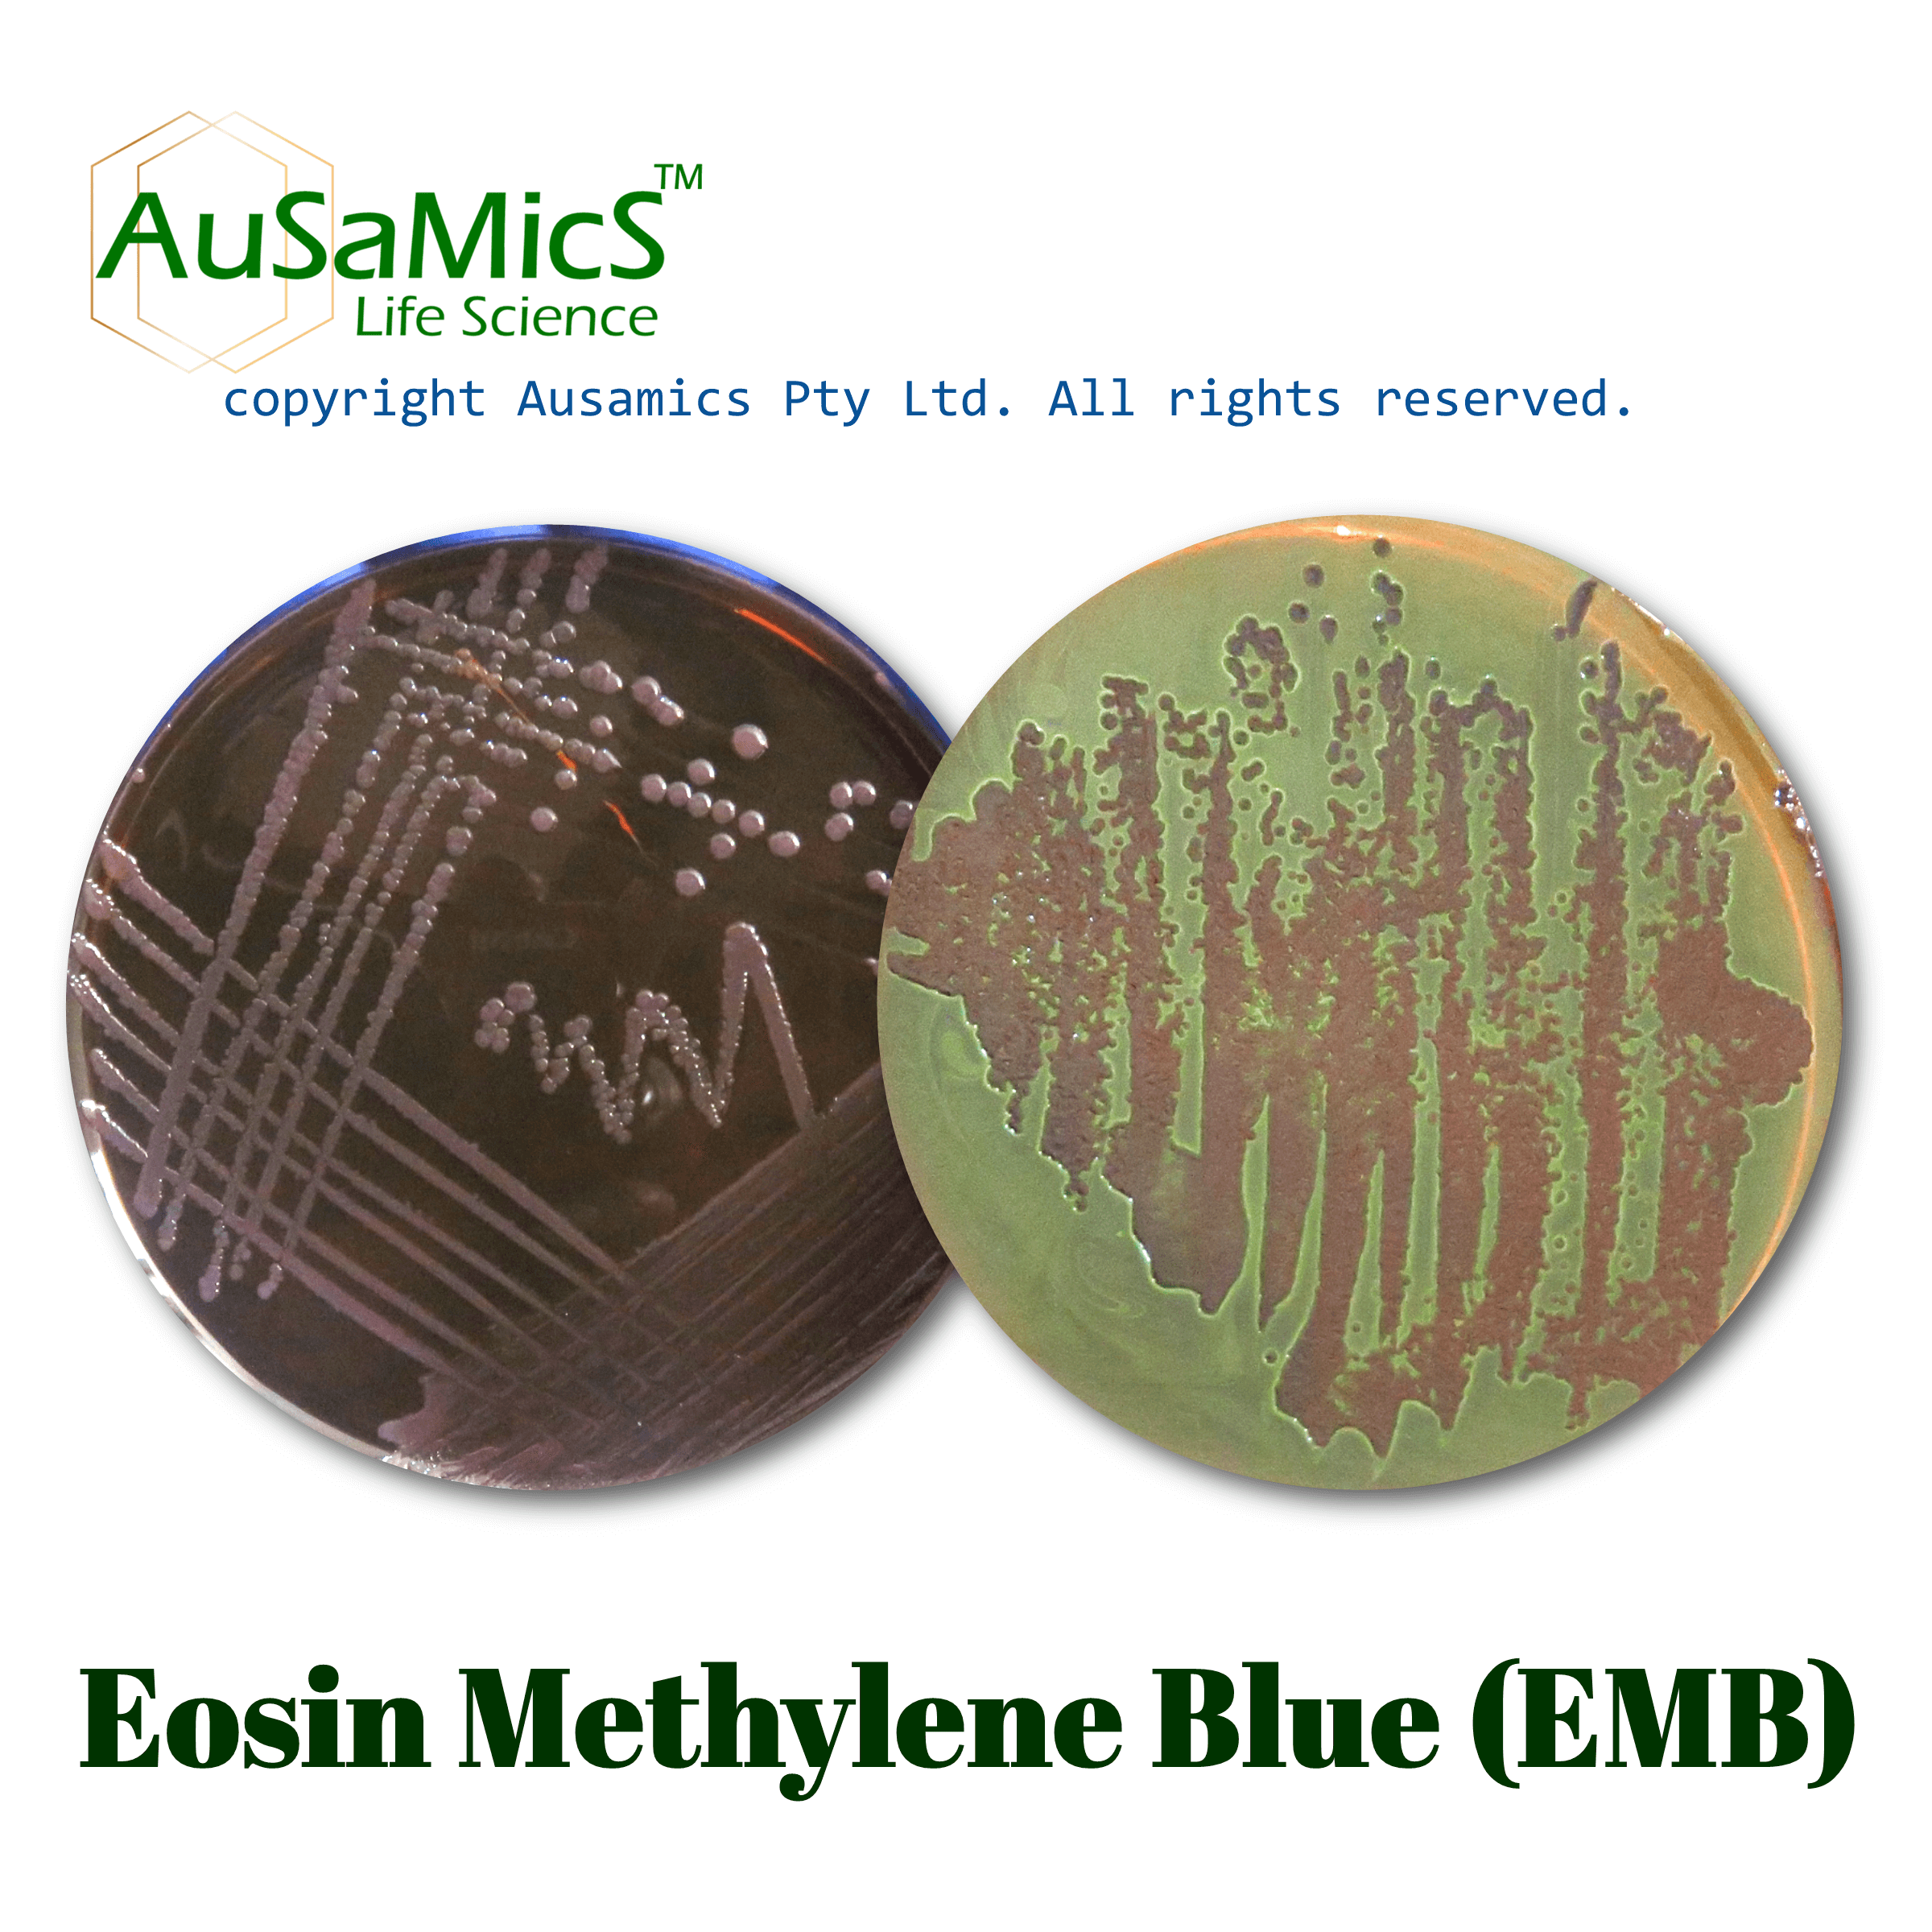
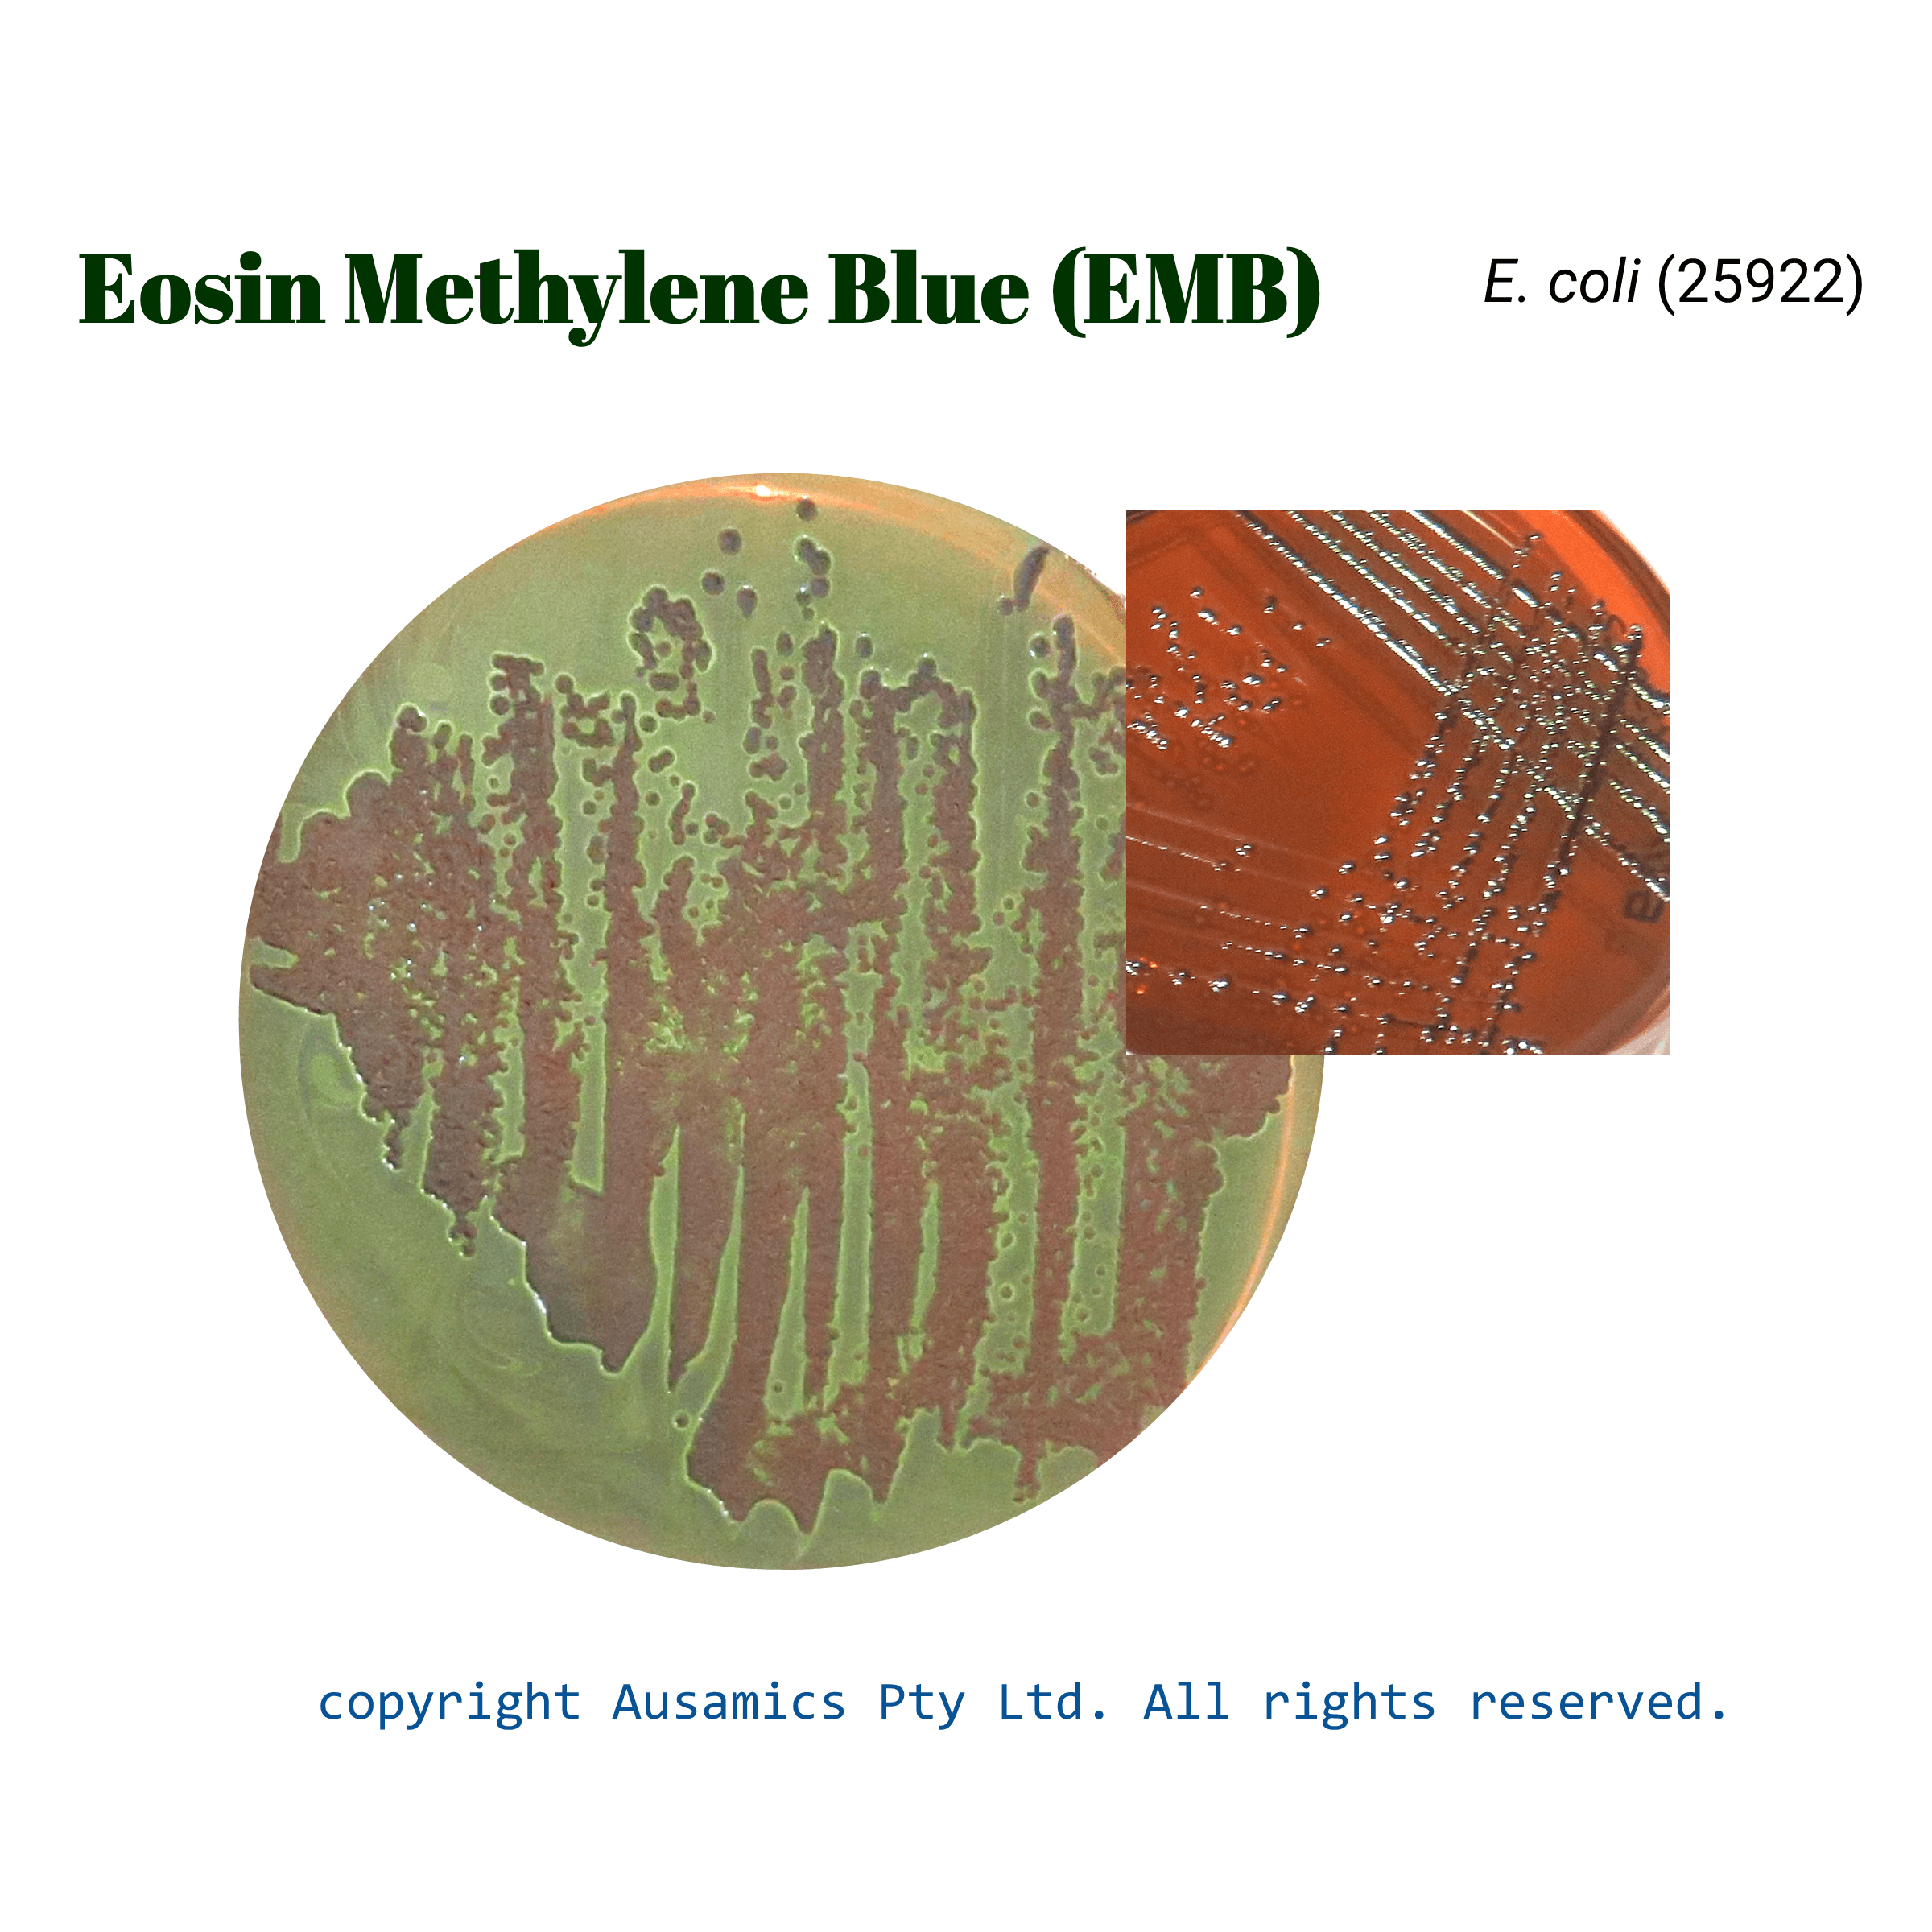
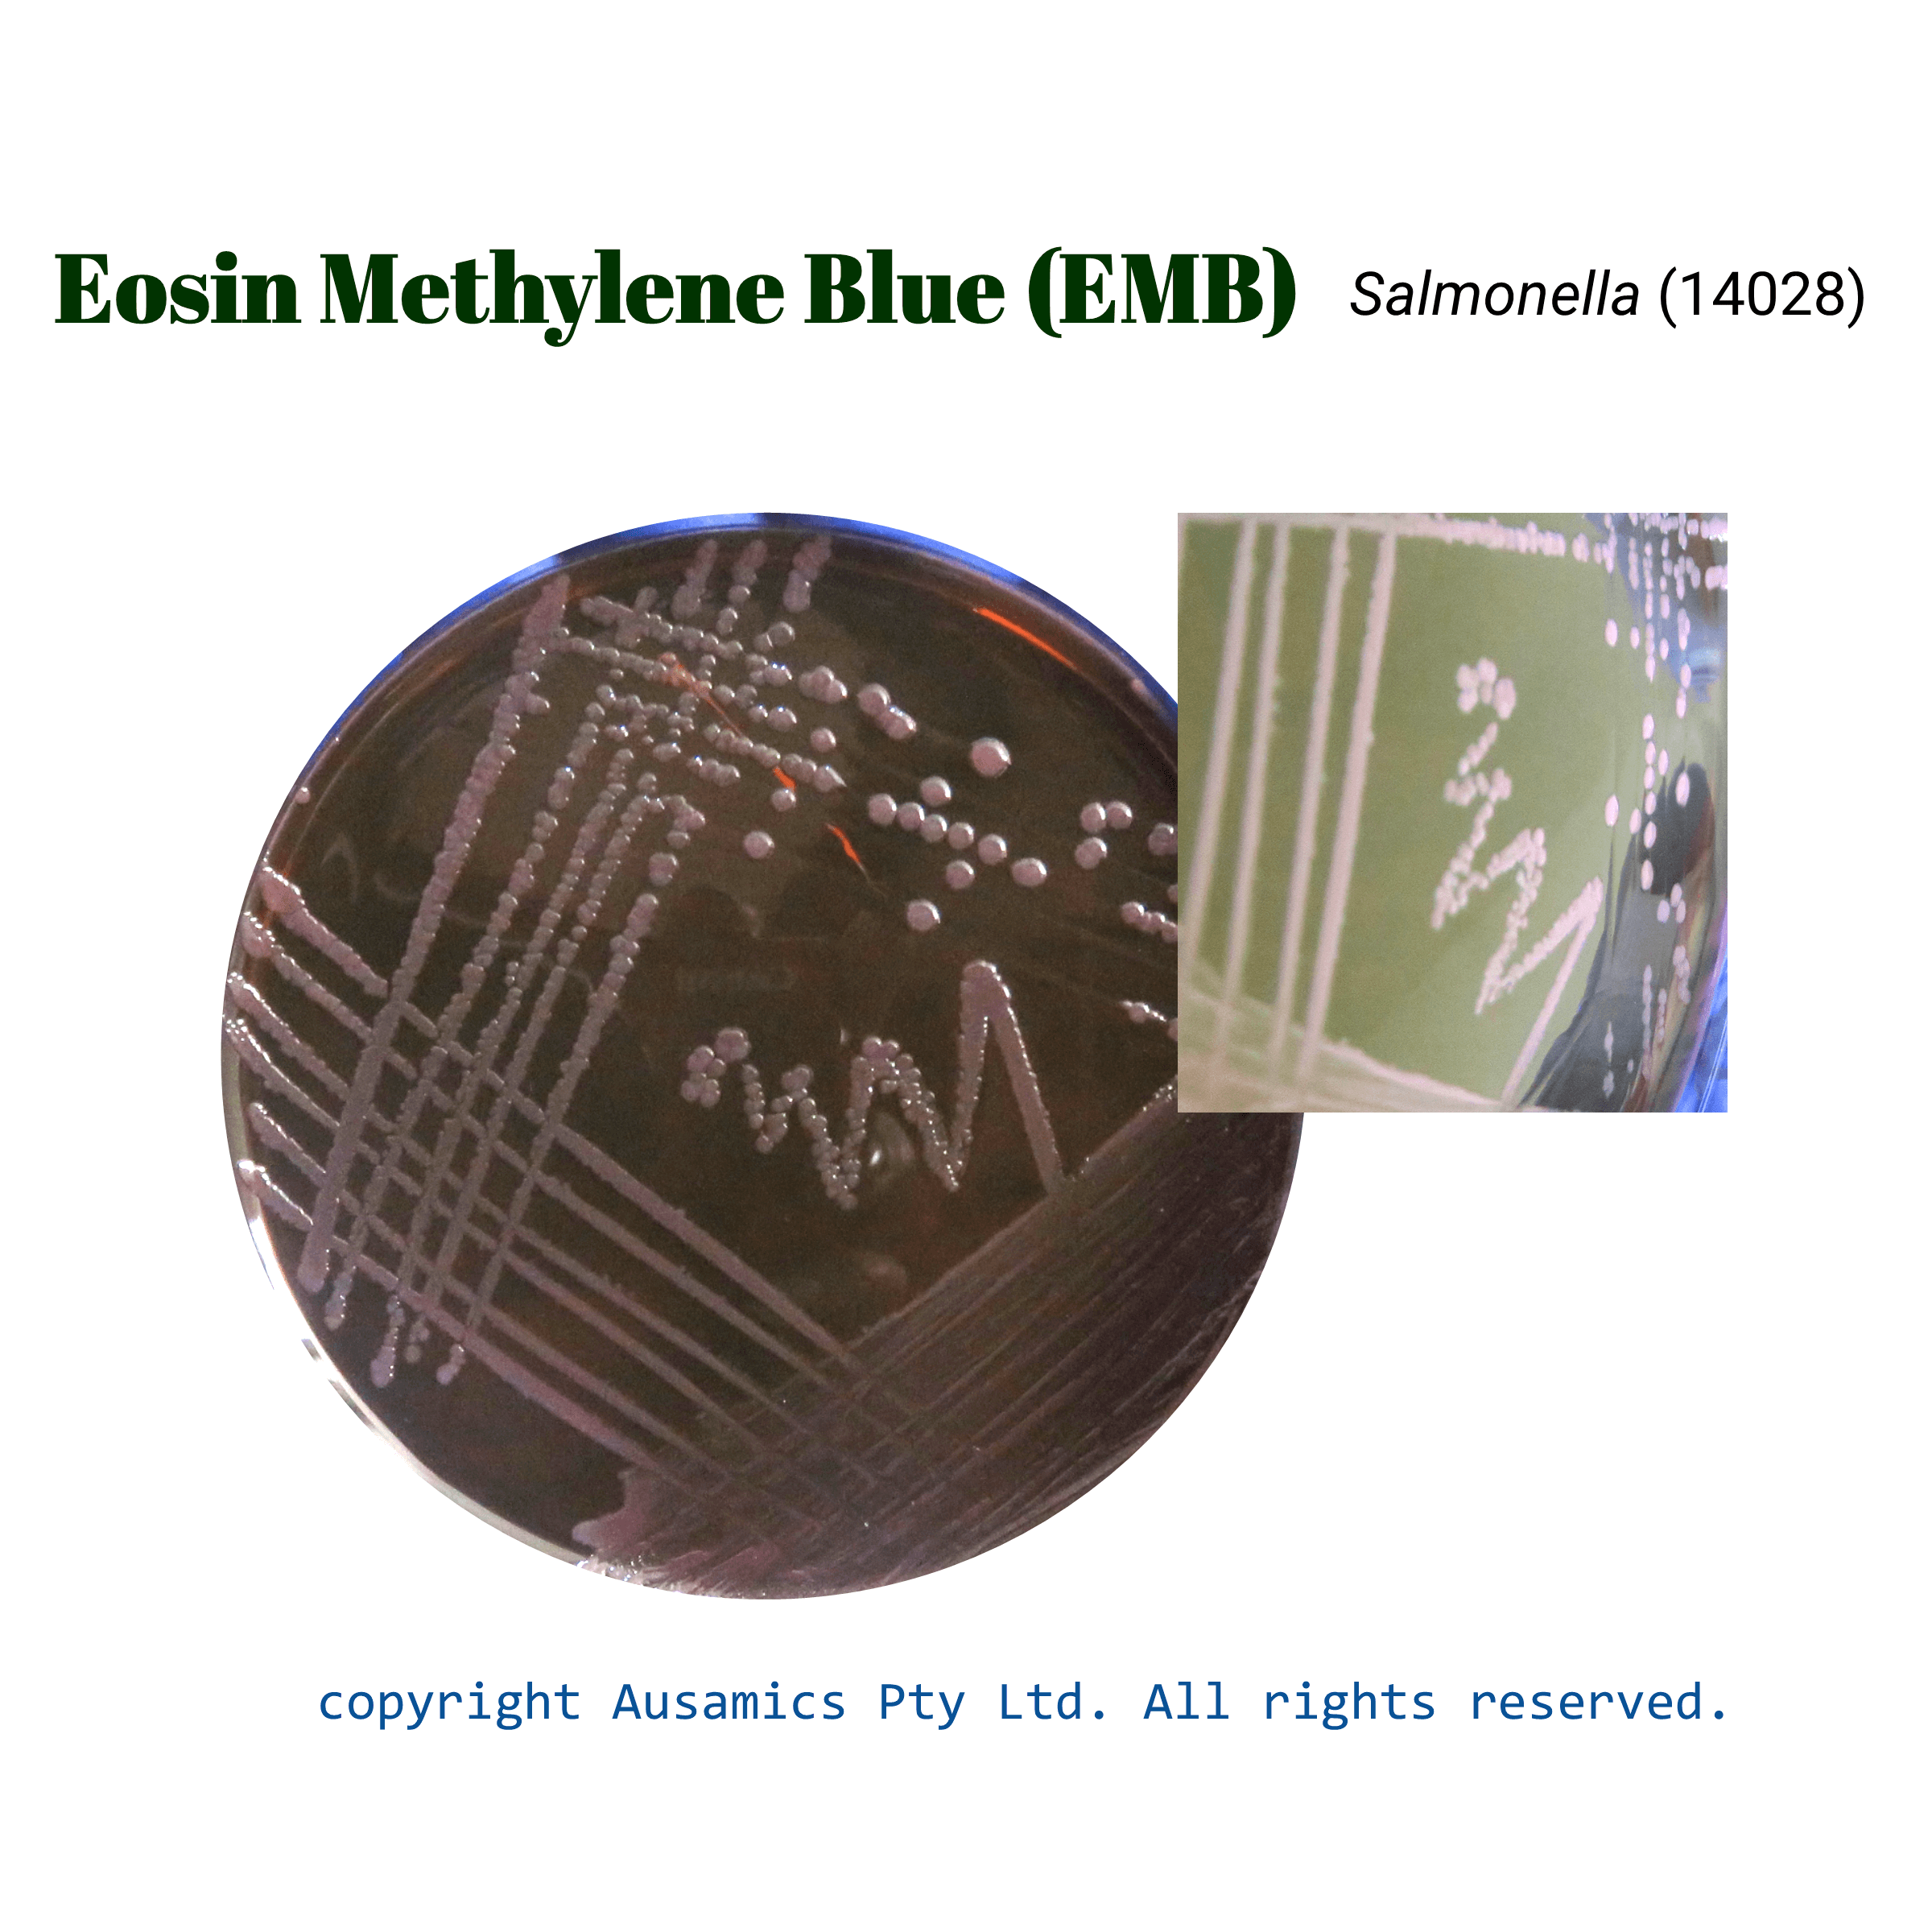

Eosin Methylene Blue Agar, EMB
A slightly selective and differential medium for isolating gram-negative enteric bacteria.
- Description
- Composition
- Quality Control
- Microbial Test Results
Enterobacteriaceae family members are isolated and differentiated using Eosin Methylene Blue (EMB) agar, a selective and differential culture medium. Lactose and sucrose are added to the medium as carbohydrate substrates, along with methylene blue and eosin Y dyes. These elements allow lactose and/or sucrose fermenters to be distinguished from non-fermenters. Dipotassium phosphate stabilizes pH while peptones supply vital nutrients. Because of dye precipitation, coliform bacteria display distinctive blue-black colonies; Escherichia coli frequently produces a metallic sheen. Colonies of non-fermenting organisms are usually colorless.
Storage
Keep the container at 15-30 °C and prepared medium at 2-8 °C.
| Composition | gr/L |
| Peptone | 10 |
| Lactose | 10 |
| Dipotassium Phosphate | 2 |
| Eosin Y | 0.4 |
| Methylene Blue | 0.065 |
| Agar | 13.5 |
| Final pH at 25°C | 7.1 ± 0.2 |
| Dehydrated Appearance | Fine, homogeneous, may contain up to a large amount of minute to small dark red purple particles. |
| Prepared Appearance | Medium to dark, green orange brown, hazy. |
| Reaction of 3.6% Solution at 25°C | pH 7.1 ± 0.2 |
| Incubate at 35±2 °C for 24 hours. | ||
| Organism (ATCC) | Recovery | Reaction |
| Escherichia coli (25922) | Good | Metallic sheen |
| Enterococcus faecalis (29212) | Partial inhibition | – |
| Salmonella enterica subsp. enterica serotype Typhi (19430) | Good | No metallic sheen |
| Shigella flexneri (12022) | Good | No metallic sheen |